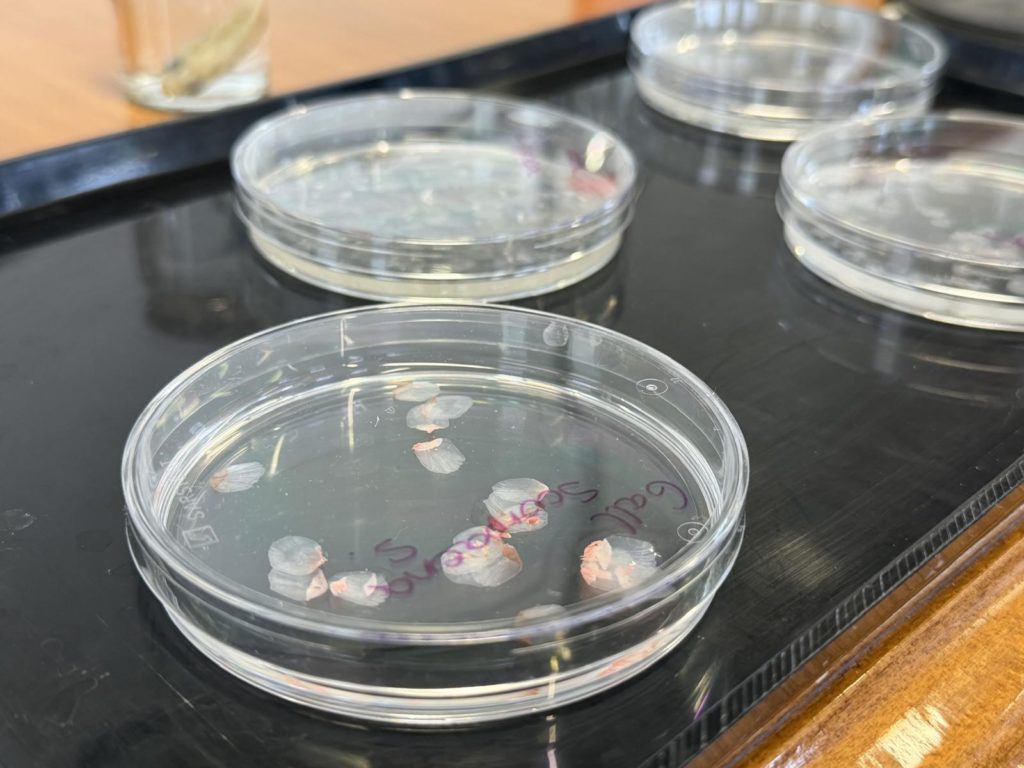

Científicos del Grupo de Ingeniería Tisular del ibs.GRANADA y la UGR desarrollan una córnea artificial a base de escamas que ya ofrece resultados prometedores en laboratorio y en pruebas con animales
Las escamas de los peces, una solución revolucionaria para regenerar la córnea humana
Las enfermedades graves que afectan a la parte transparente del ojo, llamada córnea, son muy difíciles de tratar, debido a que esta estructura carece de vasos sanguíneos y tiene escasa capacidad de regeneración y reparación. Muchos pacientes con graves patologías corneales solo pueden ser tratados mediante un trasplante, consistente en retirar la córnea dañada y sustituirla por una córnea sana procedente de otra persona que ha donado sus órganos.
Ahora, investigadores del Grupo de Ingeniería Tisular del Departamento de Histología de la Facultad de Medicina de la Universidad de Granada y del Instituto de Investigación Biosanitaria ibs.GRANADA han creado implantes corneales altamente biocompatibles, resistentes y transparentes, a partir de escamas de varios tipos de peces comúnmente encontrados en el mercado, como las carpas.
“Aunque el trasplante común suele ofrecer buenos resultados, es necesario desarrollar nuevos métodos eficaces en la regeneración que no dependan de la donación de órganos, sujeta a listas de espera”, explica Miguel Alaminos, investigador responsable del grupo TEC03- Ingeniería Tisular del ibs.GRANADA y catedrático de Histología de la UGR.
El análisis exhaustivo de las escamas de los peces ha demostrado su utilidad potencial para la reparación y regeneración de la córnea, con buenos resultados funcionales tanto en laboratorio como en animales de experimentación a los que se ha implantado este material.
“Estos resultados permiten, no solo contar con un nuevo producto potencialmente útil para el tratamiento de las enfermedades de la córnea, sino poner en valor un recurso natural derivado de la pesca, actividad de gran importancia económica en la provincia de Granada. Debido a su origen, este producto es muy accesible, fácil de obtener y de bajo coste económico, y podría contribuir a potenciar el sector pesquero en una zona en la que se está viendo afectada por numerosas restricciones y condicionantes”, detalla la investigadora del ibs.GRANADA y catedrática de Histología de la UGR Ingrid Garzón.
La investigación, que se ha dado a conocer esta mañana con la presencia de Miguel Alaminos, Ingrid Garzón y el gerente del Hospital Universitario Clínico San Cecilio Manuel Reyes, ha sido desarrollado en los laboratorios de Ingeniería Tisular del Departamento de Histología de la Universidad de Granada, financiado con fondos del Instituto de Salud Carlos III del Ministerio de Ciencia, Innovación y Universidades de España (proyecto PI23/00335).
Referencia bibliográfica:
Garzón I, Muñoz-Hurtado J, Pereira-Martínez J, González-Gallardo C, Ionescu AM, Cardona JC, Tejada-Casado M, Pérez MM, Chato-Astrain J, Alaminos M*. Generation of novel blue natural biomaterials from fish scales for use in cornea repair and engineering. Mater Des. 2025;258:114703. doi: 10.1016/j.matdes.2025.114703